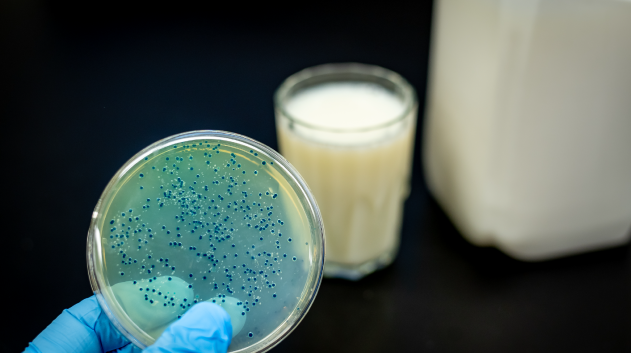

Prebiotics vs Probiotics: What’s the Difference?

If you’re evaluating gut health supplements to bring these supplements to a new territory, a clear grasp of prebiotics vs probiotics will help you choose the right formulas, make compliant claims, and position products that consumers actually understand. Below is a concise, B2B-focused guide you can share with your team and buyers.
The short answer (and why it matters)
Probiotics = Live microorganisms that, when administered in adequate amounts, confer a health benefit on the host. (4)
Prebiotics = A substrate that is selectively utilized by host microorganisms, conferring a health benefit. (2)
Put simply, probiotics add beneficial microbes, while prebiotics feed the beneficial microbes already there. Both belong in today’s trends in dietary supplements portfolios because they solve different parts of the same problem: nurturing a balanced microbiome. (6)

What buyers need to know (fast)
- Label precision for probiotics. Use full strain names and list viable counts at end of shelf life; keep copy to structure/function claims (e.g., “supports digestive health”). (4)
- Selectivity for prebiotics. Not every fiber qualifies—look for evidence of selective utilization (inulin, FOS, GOS, resistant starch). Use this distinction on PDPs and shelf tags to cut confusion. (2)
- When to combine (synbiotics). A synbiotic mixes live microbes with a substrate they—and/or host microbes—selectively use, formulated to confer a benefit (complementary or synergistic). (3)
Assortment & compliance checklist
- Definition fit: Do your SKUs actually meet the consensus definitions above? (Great for vendor calls.)
- Documentation: Ask for strain ID methods, stability, and CFU at end of shelf life; for prebiotics, proof of selective use and safety. (4)
- Claims alignment: Keep copy conservative and consistent with dossiers; NCCIH provides a useful “what we know/what we don’t” frame. (5)
- Format strategy: Capsules for simplicity; stick-pack powders or gummies for compliance and on-the-go usage, map to your price tiers and shopper missions. (6)

Distribution-ready options
When you’re planning the category, our Dr. T Probiotics line offers capsule and stick-pack formats (including targeted and synbiotic concepts) with quality documentation and region-ready dossiers, useful if you need turnkey items during a set refresh. Ask VWW for spec sheets and sell-in support.
References
- Hill C, et al. The ISAPP consensus on the scope and appropriate use of the term “probiotic.” Nat Rev Gastroenterol Hepatol. 2014. (Nature, PubMed)
- Gibson GR, et al. The ISAPP consensus on the definition and scope of prebiotics. Nat Rev Gastroenterol Hepatol. 2017. (Nature, PubMed)
- Swanson KS, et al. The ISAPP consensus on the definition and scope of synbiotics. Nat Rev Gastroenterol Hepatol. 2020. (Nature, PubMed)
- NIH Office of Dietary Supplements. Probiotics—Health Professional Fact Sheet. Updated Mar 25, 2025. (Office of Dietary Supplements)
- NCCIH. Probiotics: Usefulness and Safety and 5 Things To Know About Probiotics. (NCCIH)
- Harvard T.H. Chan School of Public Health—Nutrition Source. Probiotics (updated 2025) and Prebiotics: Understanding their role in gut health (2024). (The Nutrition Source, Harvard Health)
These statements have not been evaluated by the FDA. Products are not intended to diagnose, treat, cure, or prevent any disease.

Social Media



